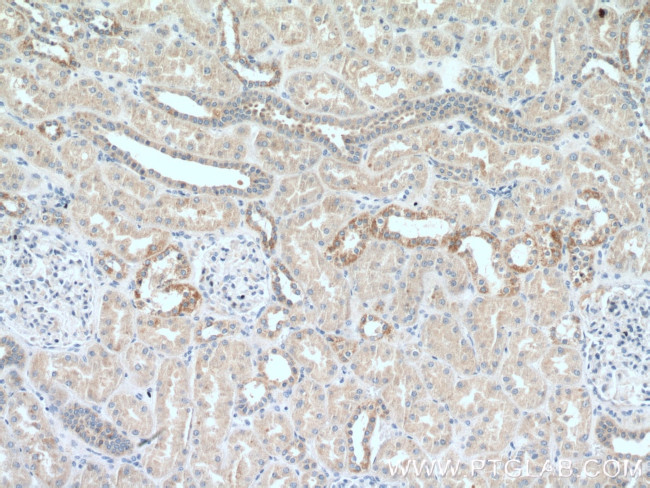
CCDC41 Antibody in Immunohistochemistry (Paraffin) (IHC (P))

Search
Proteintech
CCDC41 Polyclonal Antibody
{{$productOrderCtrl.translations['antibody.pdp.commerceCard.promotion.promotions']}}
{{$productOrderCtrl.translations['antibody.pdp.commerceCard.promotion.viewpromo']}}
{{$productOrderCtrl.translations['antibody.pdp.commerceCard.promotion.promocode']}}: {{promo.promoCode}} {{promo.promoTitle}} {{promo.promoDescription}}. {{$productOrderCtrl.translations['antibody.pdp.commerceCard.promotion.learnmore']}}
产品信息
26013-1-AP
种属反应
宿主/亚型
分类
类型
抗原
偶联物
形式
浓度
规格
纯化类型
保存液
内含物
保存条件
运输条件
产品详细信息
Immunogen sequence: MQATVRSLE AEKQSANLRA ERLEKELQSS SEQNTFLINK LHKAEREINT LSSKVKELKH SNKLEITDIK LETARAKSEL ERERNKIQSE LDGLQSDNEI LKAAVEHHKV LLVEKDRELI RKVQAAKEEG YQKLVVLQDE KLELENRLAD LEKMKVEHDV WRQSEKDQYE EKLRASQMAE EITRKELQSV RLKLQQQIVT IENAEKEKNE NSDLKQQISS LQIQVTSLAQ SENDLLNSNQ MLKEMVERLK QECRNFRSQA EKAQLEAEKT LEEKQIQWLE EKHKLHERIT DREEKYNQAK EKLQRAAIAQ KKLEQDLELG CPSVTDTYRE SVFPPPPLKR DLLK (351-693 aa encoded by B C125087)
靶标信息
Component of the distal appendage region of the centriole involved in the initiation of primary cilium assembly. May collaborate with IFT20 in the trafficking of ciliary membrane proteins from the Golgi complex to the cilium during the initiation of primary cilium assembly.
仅用于科研。不用于诊断过程。未经明确授权不得转售。
生物信息学
蛋白别名: Centrosomal protein of 83 kDa; Cep83; Coiled-coil domain-containing protein 41; NY-REN-58 antigen; Renal carcinoma antigen NY-REN-58
基因别名: CCDC41; CEP83; NPHP18; NY-REN-58
UniProt ID: (Human) Q9Y592
Entrez Gene ID: (Human) 51134